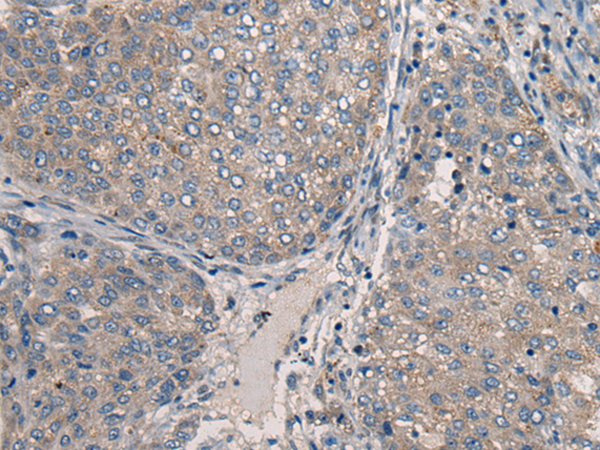
一抗

|
Background: |
This gene is one of eight which have been associated with neuronal ceroid lipofuscinoses (NCL). Also referred to as Batten disease, NCL comprises a class of autosomal recessive, neurodegenerative disorders affecting children. The genes responsible likely encode proteins involved in the degradation of post-translationally modified proteins in lysosomes. The primary defect in NCL disorders is thought to be associated with lysosomal storage function. |
|
Applications: |
ELISA, WB, IHC |
|
Name of antibody: |
CLN5 |
|
Immunogen: |
Synthetic peptide of human CLN5 |
|
Full name: |
ceroid-lipofuscinosis, neuronal 5 |
|
Synonyms: |
NCL |
|
SwissProt: |
O75503 |
|
ELISA Recommended dilution: |
5000-10000 |
|
IHC positive control: |
Human liver cancer |
|
IHC Recommend dilution: |
40-200 |
|
WB Predicted band size: |
41 kDa |
|
WB Positive control: |
231 cell lysate |
|
WB Recommended dilution: |
200-1000 |


 購物車
購物車 幫助
幫助
 021-54845833/15800441009
021-54845833/15800441009